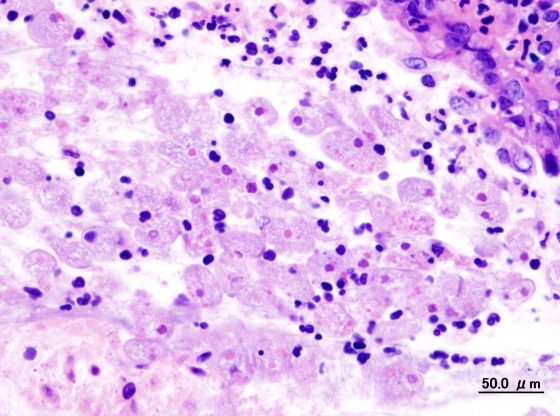

Todo nuestro cuerpo emplea un organismo de nivel acido que es conocido como PH que significa Potencial de Hidrogeno. Es un nivel mediático de acidez…
Los gatos han dejado que hablar porque han estado miles de años junto a los humanos; miles de historiadores han comentado que la introducción de…
Sin dudas china es uno de los países más desarrollados en todo el mundo; a su vez ha dejado mucho que hablar por sus tradiciones…
La disentería puede ser una enfermedad infecciosa; involucra síntomas que no son muy sencillos para tratar. La disentería no es sencilla de erradicar y los…
Generalmente el cuerpo humano se mantiene en 37 º promedio, evidentemente hay variables, pero dentro de todo mantenemos casi la misma temperatura. En caso de…